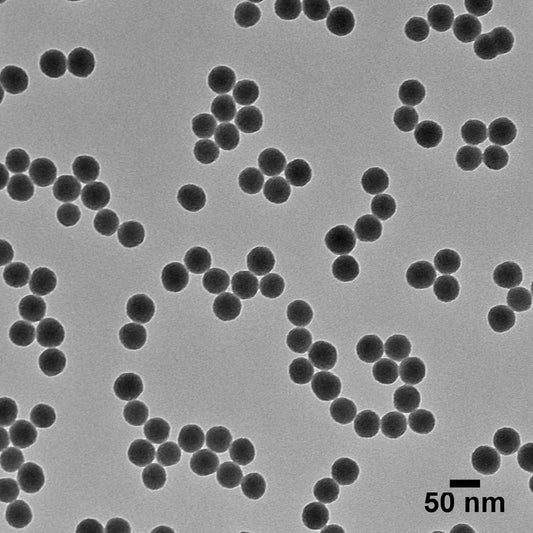
Solid Silica in Ethanol - Silica Nanospheres - Aminated - 10 mg/mL
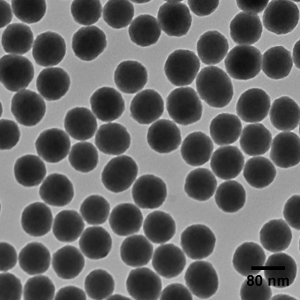

Collection: Microbial Air Samplers
-
Solid Silica in Ethanol - Silica Nanospheres - Aminated - 120 nm, 10 mg/mL
Regular price From $350.00 USDRegular priceUnit price / per -
Solid Silica in Ethanol - Silica Nanospheres - Aminated - 10 mg/mL
Regular price From $350.00 USDRegular priceUnit price / per -
Solid Silica in DI Water - Silica Nanospheres - 5 mg/mL
Regular price From $350.00 USDRegular priceUnit price / per -
Silica Nanospheres - Aminated - 20 nm, 5 mg/mL
Regular price From $380.00 USDRegular priceUnit price / per